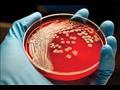
سرطان الدم

7 فحوصات طبية يجب عليك إجرائها للوقاية من الأمراض الخطيرة
كتبت-شيماء مرسي
-
عرض 6 صورة

-
عرض 6 صورة
-
عرض 6 صورة

-
عرض 6 صورة

-
عرض 6 صورة

-
عرض 6 صورة

بغض النظر عن عمرك، من الضروري دائمًا التأكد من أنك بصحة جيدة، لكن الأمر يتطلب بعض الجهد للحفاظ على صحتك، وجزء من هذا الجهد هو الحصول على اختبارات الفحص المناسبة التي تُستخدم لاكتشاف المشكلات الصحية المحتملة.
ويوضح موقع "برايت سايد"، 7 فحوصات طبية يجب على كل بالغ الخضوع لها للوقاية من الأمراض الخطيرة؟
1- فحوصات الجلد:
وفقًا لنتائج دراسة أجرتها جمعية السرطان الأمريكية، يتم تشخيص حوالي 3.3 مليون أمريكي بسرطان الجلد كل عام، فقط لكي تكون آمنًا، تحقق من نفسك مرة واحدة في الشهر بدءًا من سن 18 عامًا، وتستند الفحوصات التي يقوم بها أخصائي طبي إلى عوامل الخطر لدى المريض.
وقد تشمل عوامل الخطر هذه:
التعرض لأشعة الشمس بشكل كبير.
تاريخ عائلي للإصابة بسرطان الجلد.
وجود شامات متعددة غير عادية.
تاريخ من العديد من حروق الشمس، خاصة في وقت مبكر من الحياة.
وأثناء إجراء الفحوصات يقوم طبيب الأمراض الجلدية المعتمد بفحص الجلد على كامل الجسم (بما في ذلك فروة الرأس والأعضاء التناسلية وبين أصابع قدميك)، ويبحث عن أورام أو شامات أو آفات مشبوهة.
2- فحص الكوليسترول:
يتم قياس الكوليسترول عن طريق فحص الدم وقد يطلب منك طبيبك عدم تناول الطعام لمدة 9 إلى 12 ساعة قبل ذلك، وبشكل عام، سيقيس اختبار الكوليسترول مستويات الكوليسترول الكلي، والكوليسترول الحميد (الجيد)، والكوليسترول الضار (السيئ)، والدهون الثلاثية.
ووفقًا لجمعية القلب الأمريكية (AHA)، يجب فحص الكوليسترول لدى جميع البالغين الذين تزيد أعمارهم عن 35 عامًا كل 5 سنوات، كما يجب أن يبدأ الفحص في سن العشرين إذا كان لديك بعض عوامل الخطر مثل:
داء السكري.
التدخين.
مؤشر كتلة الجسم فوق 30.
تاريخ عائلي من السكتة الدماغية.
أقارب من الدرجة الأولى أصيبوا بنوبات قلبية.
3- فحص الحوض ومسحة عنق الرحم:
يجب أن تخضع كل امرأة تبلغ من العمر 21 عامًا أو أكثر لفحص الحوض أو مسحة عنق الرحم كل 3 سنوات، ويتم إجراء هذا الاختبار للتحقق من وجود علامات لسرطان عنق الرحم، ووفقًا لجمعية السرطان الأمريكية، على مدار الخمسين عامًا الماضية، انخفض معدل الوفيات من هذا المرض بأكثر من 74٪ بفضل مسحة عنق الرحم.
4- مرض السكري:
يجب فحص مرض السكري على جميع البالغين مرتين على الأقل في السنة لأنه لا يظهر أي أعراض في سن مبكرة، ولكن يجب أن تخضع للاختبار بالتأكيد إذا واجهت أيًا من الأعراض المبكرة التي تحدث أحيانًا، بما في ذلك:
العطش الشديد.
الشعور بالتعب طوال الوقت.
الشعور بالجوع الشديد، حتى بعد الأكل.
رؤية ضبابية.
التبول أكثر من المعتاد.
لديك تقرحات أو جروح لا تلتئم.
وقد يشمل اختبار مرض السكري اختبار الدم الهيموجلوبين A1C أو اختبار الجلوكوز في بلازما الصيام (FPG) أو اختبار تحمل الجلوكوز الفموي (OGTT).
5- التهاب الكبد:
يشير التهاب الكبد إلى حالة التهابية في الكبد، وعادة ما يكون سببها عدوى فيروسية، ولكن هناك أسباب أخرى محتملة لالتهاب الكبد، وفي كثير من الأشخاص، يمكن أن تكون أمراض الكبد صامتة، وإذا لم تكن لديك أعراض، فقد يؤدي التهاب الكبد C إلى إضعاف جهاز المناعة لديك وقد يؤدي إلى تليف الكبد أو سرطان الكبد إذا تُرك دون علاج، ووفقًا لمراكز السيطرة على الأمراض والوقاية منها (CDC)، يعيش ما يقرب من 4.4 مليون أمريكي حاليًا مصابين بالتهاب الكبد المزمن B أو C، ولا يعرف الكثير من الأشخاص أنهم مصابون بالتهاب الكبد.
6- سرطان الدم:
من الضروري الحصول على تحليل عام لدمك، كما إنه مهم للكشف المبكر عن سرطان الدم، ويوجد 137 نوعًا مختلفًا من سرطان الدم ولكن الأنواع الثلاثة الرئيسية هي سرطان الدم والورم الليمفاوي والورم النخاعي.
وغالبًا ما يمكن تشخيص سرطان الدم من خلال فحص دم بسيط يساعد في اكتشاف ما يلي:
للمساعدة في تشخيص بعض أنواع سرطانات الدم، مثل اللوكيميا والأورام اللمفاوية.
معرفة ما إذا كان السرطان قد انتشر إلى نخاع العظام.
تحديد كيفية تعامل جسم الشخص مع علاج السرطان.
لتشخيص الحالات غير السرطانية الأخرى.
7- اختبار كثافة العظام:
لم يفت الأوان بعد لفحص كثافة عظامك، ويصيب هذا الضعف الشديد للعظام ما يقرب من 10 ملايين أمريكي من كبار السن، و80٪ منهم من النساء، وفقًا لمؤسسة هشاشة العظام الوطنية عليك فقط إعطاء عينة من البول تقيس المعدل الذي تفقد به كتلة العظام متبوعًا بأشعة إكس (اختبار DXA) سنويًا، وإذا أظهرت الأشعة السينية أنك تعاني من هشاشة العظام، وهي حالة ما قبل هشاشة العظام ذات كثافة عظام منخفضة، فسوف يوصي طبيبك باستهلاك ما لا يقل عن 1000 مجم من الكالسيوم و 400 إلى 800 وحدة دولية من فيتامين د يوميًا.




























